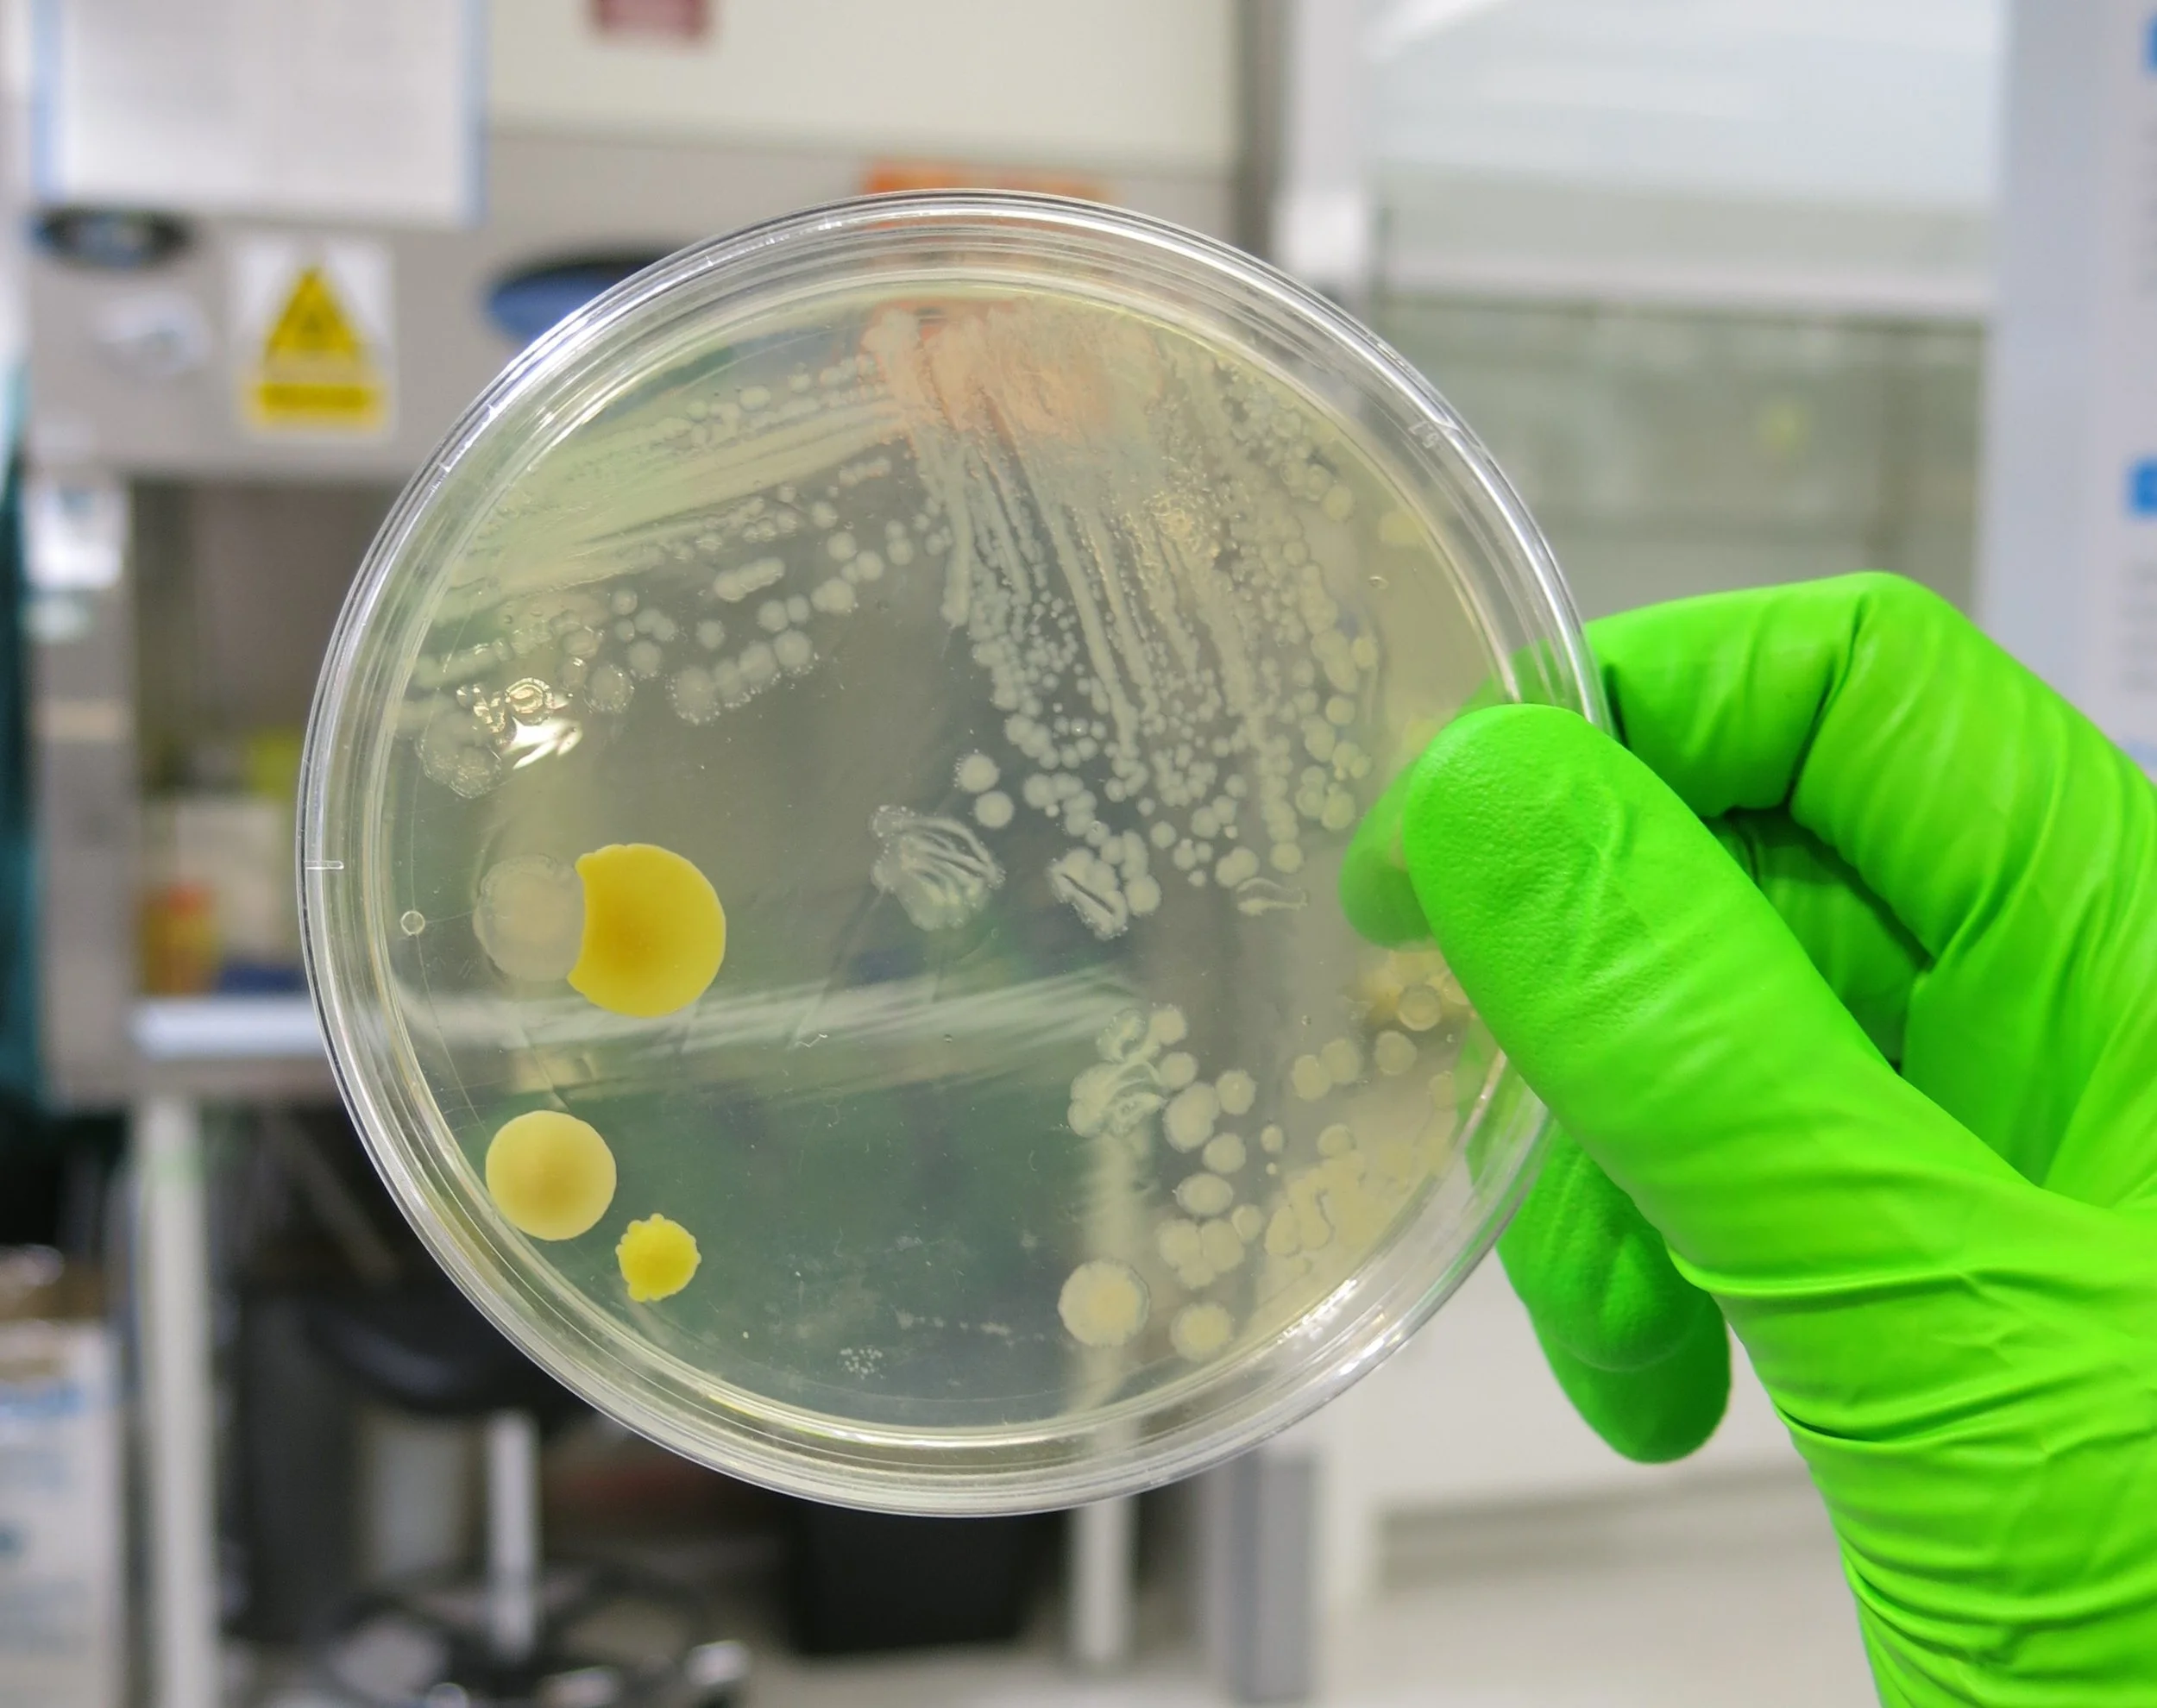

Digital Health Hub for AMR featured in Podcast with The Naked Scientists: AMR unleashed - The Silent Pandemic
In a recent episode of the Naked Scientists podcast, experts from the Digital Health Hub for AMR and the UK Health Security Agency shed light on the growing threat of AMR, the current landscape and potential solutions.
Laura Shallcross, Director of UCL’s Institute of Health Informatics, and a deputy director of the Hub, sets the scene by mentioning how AMR is not a new phenomenon. Since the discovery of antibiotics by Alexander Fleming, resistance has been a looming threat. However, the current crisis is exacerbated by the slow progress of new antibiotic development pipelines.
Mark Sutton, Scientific Leader at UKHSA Porton Down and Professor of Antimicrobial Therapy at King’s College London, highlighted the economic barriers to antibiotic development. He discusses the measures the UK has in place to help incentivise companies to invest in antibiotic research.
Andrew Singer, Principal Scientist at the UK Centre for Ecology & Hydrology and a deputy director of the Hub discussed the importance of global collaboration in combating AMR. He mentioned the need for a trusted research environment where genetic sequences of resistant microbes are shared internationally. This approach would enable better understanding and prevention of AMR by identifying sources and transmission pathways.
Colin Brown, Infectious Diseases Clinician and Public Health Microbiologist at UKHSA and a Deputy Director of the Hub discussed the interconnectedness of human health, animal health, and environmental factors. He stressed the need for a "One Health" approach that integrates policies across different sectors to reduce antibiotic resistance.
Listen to the full episode here: https://www.thenakedscientists.com/podcasts/naked-scientists-podcast/amr-unleashed-silent-pandemic